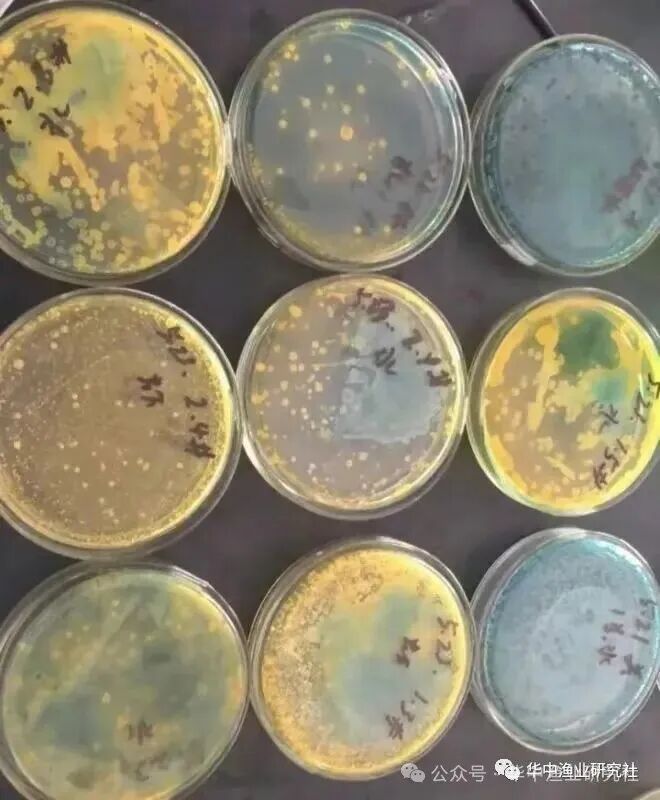
369409d1178fb2ba6474c28f403ca0e5.jpg

对虾养殖如何科学防控弧菌
更新时间:2026-01-21 10:34:55 来源/作者:华中渔业研究社
对虾养殖过程中有一种令人十分头疼的有害菌叫做弧菌,弧菌感染可引起肝胰腺坏死,空肠空胃,偷死等各种绝症。今天小编就来分享一下弧菌的种类以及防控,供大家参考:

一、什么是弧菌?
弧菌是海洋环境中常见的细菌类群之一,该类细菌具有很强的适应性和抗逆性,因此成为海水环境的优势种群,常作为致病菌引起疾病的爆发流行。
对虾养殖中常见的弧菌有:副溶血弧菌、溶藻弧菌、创伤弧菌及鳗弧菌;弧菌属细菌能引起对虾弧菌病,是目前对虾养殖过程中最为常见、危害最大的细菌性疾病。
二、弧菌的生活习性:
1、弧菌适应温度:10-35℃,最适25℃左右;
2、生长需要盐度:一般在0.5-6%,最适1%,溶藻弧菌可以在7-10%的盐度下生长。可见,弧菌在半咸水和海水中很多,在淡水中较少。这也就是淡水养殖对虾,弧菌病发病率较低,养殖成功率较高的主要原因。
弧菌的繁殖速度随着盐度的增加和温度的增加而加快,据调查显示一个弧菌分裂繁殖一代(变成2个弧菌)也只需要10分钟。
3、弧菌的感染途径:主要是经口传播,其次是通过体表创伤和腮进入体内。虾在2-4厘米时经常出现爬沙现象(高位池出现浅水区集群),多为觅食活动,虾苗摄食沙里的微生物,这时极易误食池底大量滋生的弧菌,若再赶上水体、天气变化,虾苗体质下降,很容易就“中镖”了。高位池薄膜上厚厚的藻膜也在这时候被虾慢慢摄食掉,藻膜中同样含有大量弧菌,对虾也容易被感染。

三、弧菌的致病机理:
弧菌的胞外产物(如酯酶、蛋白酶、磷酸酯酶、溶血素和几丁质等)主要是通过产生蛋白酶或者促使机体组织释放蛋白酶而造成组织溶解,具体表现形式如下:
1、运动的自主性及粘附作用
2、妨碍对虾血液凝固
3、破坏对虾体组织、引发炎症
4、降低对虾免疫力

四、如何科学防控弧菌:
(一)选择健康的虾苗
可以到相应检测中心进行检测,选择健康不带弧菌病原的虾苗,是养殖成功的首要步骤;

(二)阻断弧菌传播途径
(1)有些朋友喜欢消毒处理。弧菌对目前水产市场上的常见的消毒药都非常敏感,不需要找什么高大上的产品。二氧化氯、碘等都能有效的杀灭弧菌;
(2)实际操作的关键是,降低池塘有机物后再消毒,会事半功倍;
(3)消毒后,应立即补充有益菌(芽孢杆菌、光合细菌乳酸菌、EM菌),使有益菌群优势恢复。
(三)控制对虾体内弧菌
(1)有些人使用抗生素类药物治疗,本人不推荐。因为使用抗生素后,虾的生长有“受阻”的趋势。
(2)从体质入手,所有外源性的消杀,都是为了减少弧菌进入虾体内的数量。对虾体质强,弧菌感染后就不容易发病,能够有效的抵御弧菌的侵袭。
(3)采用“菌相 + 藻相 + 噬菌体”的生物控制方案,不到非用不可,尽量减少消杀类产品的应用。但蛭弧菌噬菌体,目前市面上五花八门,这种产品的筛选,是要“交学费”的,没有多次的对比,难以找到适合自己塘口的产品。
(四)避免盲目消杀
盲目消毒是造成南美白对虾弧菌爆发的一大诱因。消毒会破坏池塘菌群平衡,打破水体藻菌平衡,导致弧菌繁殖速度快,消毒实际上是为弧菌提供良好的生长机会。实践中,经常会遇到,使用消毒剂后第三天,弧菌爆发,对虾发病的状况。把水体的弧菌杀个干干净净,显然是不现实的,如果只靠消杀来养虾,那只能是越养越差,把思路转变一下,控制弧菌反而更轻松。
每日更新
重点推荐
友情链接
【政府部门】: 农业农村部 | 广东省农业农村厅 | 全国水产技术推广站
【科研院所】: 华南农业大学 | 中山大学 | 广东海洋大学 | 仲恺农业工程学院 | 上海海洋大学 | 中国水产科学研究院珠江水产研究所 | 中国水产科学研究院南海水产研究所
咨询服务:020-34466381 | 合作服务:18620920190 | 会员服务: 020-34466381
地 址:广州市南沙区东涌镇市南路4号段广东海洋与水产高科技园4号楼 邮编:511453
Copyright 2006-2019广东省水生动物卫生协会版权所有
返回顶部